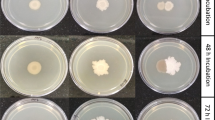

Abstract
Successful colonization is the initial step for plant-bacteria interactions; therefore, the development of strategies to improve adherence to plant surfaces is critically important for environmental bacteria. Biofilm formation is thought to be one such strategy for bacteria to establish stable colonization on inert and living surfaces. Although biofilms play potential roles in enabling persistent bacterial colonization, little attention has been paid to biofilms formed by plant-associated bacteria. In this study, we characterized the biofilm-forming ability of 6 species of bacteria from the family Pseudomonadaceae: Pseudomonas protegens, Pseudomonas fluorescens, Pseudomonas putida, Pseudomonas stutzeri, Pseudomonas mendocina, and Pseudomonas syringae. These strains exhibit different degrees of biofilm formation depending on incubation time and nutrient availability. Distinct preferences for growth media were observed, as biofilms were formed by P. protegens with rich nutrients and by P. fluorescens and P. putida with poor nutrients. Likewise, P. stutzeri did not form biofilms with rich nutrients but did form biofilms under nutrient-poor conditions. These observations indicate that particular components in media may influence biofilm formation. P. putida, one of the strains with high biofilm-forming ability, showed the highest ability for initial attachment, which may be mediated by the hydrophobicity of its cell surface. P. mendocina also has high ability for initial attachment, and this strain produces cell surface-attached extracellular polysaccharides that promote cell aggregation. Thus, each strain possesses different properties that facilitate biofilm formation. Shedding light on bacterial strategies for colonization via biofilm formation would enable a better understanding of plant–bacteria interactions.
Similar content being viewed by others
Avoid common mistakes on your manuscript.
Introduction
Bacteria have two different lifestyles: a motile form in aqueous environments and a sessile form on liquid–solid interfaces. The former is a freely swimming style driven by flagellar motility, and the latter is a cell-to-cell aggregated style mediated by so-called biofilms. In natural environments, many bacterial species live in biofilms that adhere to both living and inert surfaces. Biofilms are densely packed bacterial communities that encase bacterial aggregates in a complex hydrated matrix of extracellular polysaccharides (EPS), extracellular DNAs (eDNA), and proteins [22, 29]. In developing biofilms, bacteria grow slowly at locations at which they are attached and establish biofilm architectures by continuous production of eDNA and EPS. Consequently, bacteria inside biofilms increase the size of their population while staying at the same place, and expand their colonizing area by expanding the biofilm. In addition, bacterial cells in biofilms acquire resistance against antimicrobials because well-developed biofilm structures inhibit the penetration of antimicrobials [2]. Due to these characteristics, infections by pathogens with ability to form biofilms often become persistent, as seen in the case of infections by Pseudomonas aeruginosa, an opportunistic pathogen, in cystic fibrosis [22]. Thus, the biological functions of biofilms are characterized as follows: (1) they provide an abode for bacterial cells that enables them to colonize surfaces persistently, (2) they facilitate the stable growth of bacterial populations on colonized sites, and (3) they increase tolerance to antimicrobial compounds. Therefore, elucidating the mechanisms of biofilm formation and discovering tools to control bacterial biofilm formation are emerging topics in the study of plant–bacteria interactions [1].
The process of biofilm formation consists of four steps: initial attachment, EPS and eDNA production, biofilm maturation, and biofilm dispersion [17]. Freely floating bacteria initiate the formation of biofilms by attaching to solid surfaces and releasing EPS and eDNA, thereby establishing biofilm layers that enable additional bacteria to adhere. Continuous production of EPS and eDNA induces the mature biofilm structure, as seen in the mushroom-shaped biofilms formed by P. aeruginosa [12]. If part of a highly developed biofilm structure is collapsed for any reason, the bacteria released from the biofilm establish another biofilm community at another location. Thus, each stage of the life cycle of biofilms is governed by different biological processes.
Bacterial cells inside biofilm communities communicate during biofilm formation using different types of chemical tools. 3′,5′-Cyclic-di-guanylate (c-di-GMP) regulates switching the bacterial lifestyle from the motile form to the sessile form [21]. Increasing cellular c-di-GMP concentration facilitates bacterial attachment to surfaces and the production of EPS and eDNA and represses flagellar motility; therefore, it is a positive regulator of biofilm formation [27, 28]. On the other hand, cis-2-decenoic acid has been shown to be a negative regulator of biofilm formation, because addition of this fatty acid in biofilms promotes biofilm dispersion [3]. In P. aeruginosa, the model bacteria for biofilm research, two different classes of quorum–sensing molecules control the development of biofilm structures [4], and it has been proposed that quorum sensing regulates biofilm formation via c-di-GMP production [27]. Environmental cues, including pH, nutrients, temperature, and so on, also influence biofilm formation via the production of these signal molecules, although the responses to these factors vary among bacterial species. In addition, cell surface properties affect biofilm formation, as bacteria with hydrophobic properties have a better ability for initial attachment and biofilm formation [6]. Thus, biofilm formation is governed by various factors.
Crop plants interact with environmental bacteria both in the rhizosphere, which surrounds root surfaces, and in the phyllosphere, which surrounds shoot surfaces. For example, beneficial bacteria promote plant growth by providing nutrients, hormones, and unknown molecules, and pathogenic bacteria cause disease symptoms by attacking host cells with toxins. In host–bacteria interactions, bacterial attachment on host surfaces is the first step that controls successful colonization. However, the relevance of biofilm formation on host growth has yet to be understood in terms of plant–bacteria interactions because of the limited information available on biofilm formation by plant-associated bacteria [13]. Pseudomonads are ubiquitous inhabitants of water, soil, and plant surfaces, and some species interact with plants, either as beneficial or pathogenic bacteria [19]. In this study, we examined the profiles of biofilm formation by Pseudomonas protegens, Pseudomonas fluorescens, and Pseudomonas putida as beneficial bacteria [15, 24], Pseudomonas stutzeri and Pseudomonas mendocina as nonpathogenic bacteria [7, 30], and Pseudomonas syringae as a pathogenic bacterium [20]. An investigation of the ability of these plant-associated bacteria to form biofilms would provide a better understanding of how they influence plant growth via the phyllosphere or rhizosphere.
Materials and Methods
Bacterial Strains and Growth Conditions
Bacterial strains used in this study were as follows: P. protegens Pf-5, P. fluorescens Pf0-1, P. putida KT2440, P. stutzeri A1501, P. mendocina NBRC 14162, and P. syringae B728a. Bacteria were routinely grown at 28 °C in Luria–Bertani (LB) medium (10 g/L tryptone, 5 g/L yeast extract, 10 g/L NaCl), M9 minimal medium (6 g/L Na2HPO4, 3 g/L KH2PO4, 1 g/L NH4Cl, 0.5 g/L NaCl, 0.25 g/L MgSO4 7H2O, 0.2 % (w/v) glucose), or King’s B (KB) medium (20 g/L peptone, 1.5 g/L KH2PO4, 1.5 g/L MgSO4 7H2O, 1 % (w/v) glycerol) at 125 rpm.
Biofilm Formation
Biofilm formation was examined in 96-well polystyrene plates as described previously [25, 26]. Briefly, bacterial overnight cultures were diluted with fresh medium to a turbidity of 0.05 at 600 nm, and then 150 μL of each bacterial culture was incubated per well in 96-well polystyrene plates for 2, 4, 8, 24, and 48 h at 28 °C without agitation. Three to six wells were used for each strain, and 2 independent cultures were tested. After incubation, turbidity was monitored at 620 nm to estimate the amount of free-living bacterial cells that did not participate in forming biofilms. Plates were rigorously washed 3 times with distilled water, and biofilms were stained with 0.1 % (w/v) crystal violet for 30 min at room temperature. After staining, plates were again washed 3 times with distilled water and then were air-dried for 30 min. To quantify biofilms, 200 μL of 95 % ethanol was added to each well, and the absorbance was measured after vigorous shaking for 30 s at 540 nm using a microplate reader (Sunrise, TECAN, Switzerland).
Phenotypic Characterization
Bacteria grown in LB medium at 28 °C were diluted to a turbidity of 0.001 at 600 nm with fresh LB medium and 2 μL of diluted bacterial culture was spotted onto an LB plate to observe colony morphology or a Congo red plate (10 g/L peptone, 40 μg/mL Congo red, 20 μg/mL Coomassie brilliant blue R250) to investigate Congo red absorption by bacterial colonies [8]. Plates were incubated at 28 °C for 5 days. Pellicle formation was tested under static culture conditions. Five milliliters of the diluted bacterial culture mentioned above was placed in a sterilized polycarbonate glass tube. After incubation at 28 °C for 7 days, pellicle formation was determined by observing whether floating biofilms had developed in the interface between air and liquid.
Initial Attachment
To estimate the ability of bacteria for initial attachment onto a polystyrene surface, bacterial overnight cultures were diluted to a turbidity of 1.0 at 600 nm with fresh LB medium, and 150 μL of diluted bacterial culture was added to each well of 96-well polystyrene plates. Three wells were used for each strain, and 2 independent cultures were tested. After incubation at 28 °C for 15, 30, and 60 min, each well was washed gently by pipetting and stained with 0.1 % (w/v) crystal violet as described above, except that in this case, to maximize detection of attached bacteria, washing was carried out by gentle pipetting. Initial attachment for each strain was monitored at 540 nm using a microplate reader.
Cell Surface Hydrophobicity
Surface hydrophobicity of bacterial cells was determined as described previously [31]. Briefly, bacterial cells grown in LB medium were collected by centrifugation at 15,000g for 2 min and washed with PUM buffer (150 mM potassium phosphate, 30 mM urea, 0.8 mM MgSO4, pH 7.0). Bacterial cells were then collected by centrifugation again and resuspended in PUM buffer to a turbidity of approximately 2.5 at 600 nm. One milliliter of cell suspension was vigorously mixed in glass tube with 500 μL of xylene for 1 min, and then the tube was placed at room temperature for 30 min. This procedure allows for bacterial cells with a hydrophobic cell surface property to be captured in the xylene layer and at the xylene–PUM interface. Thus, it was possible to calculate cell surface hydrophobicity (%) with the following equation: (turbidity of PUM layer at 600 nm with xylene)/(turbidity of PUM layer at 600 nm without xylene) × 100.
EPS Production
EPS production was determined as follows. The amount of EPS attached to bacterial cell surfaces was quantified as described previously [14, 27]. Bacterial cultures grown in LB were collected by centrifugation at 15,000g for 2 min and washed with T-broth (10 g/L peptone) twice. Then, the turbidity of the bacterial culture at 600 nm was adjusted to 2.5 in T-broth with Congo red at 40 μg/mL, and the culture was then incubated at 28 °C for 2 h at 125 rpm. Next, Congo red that had attached to the EPS on cell surfaces was collected with bacterial cells by centrifugation at 15,000g for 10 min, and the concentration of Congo red remained in the supernatant was measured using Congo red standard solution. Finally, the amount of EPS attached to cell surfaces was estimated using the following equation: (amount of Congo red added in the culture) − (amount of Congo red remained in the supernatant of the culture). T-broth with 40 μg/mL Congo red was used as the blank. For EPS released in the culture medium, bacteria were grown in LB medium at 28 °C for 18 h at 125 rpm, and 500 μL of supernatant was collected by centrifugation at 15,000g for 5 min. After the addition of 1.5 mL isopropanol, the EPS was precipitated by centrifugation at 15,000g for 15 min and washed with 70 % (w/v) ethanol. EPS pellets were dissolved in 500 μL distilled water, and 200 μL of the resulting solution was incubated with 1 mL of 0.2 % (w/v) anthrone-H2SO4 at 100 °C for 7.5 min. After the absorbance at 620 nm was measured, EPS production was calculated using a glucose standard.
Results and Discussion
Characterization of Biofilm Forming Ability in Pseudomonads
To gain insight into biofilm formation by plant-associated bacteria, we characterized the biofilm-forming abilities of P. protegens, P. fluorescens, P. putida, P. stutzeri, P. mendocina, and P. syringae. We investigated two different types of biofilms formed by these bacteria: surface-attached biofilms (Fig. 1a) and floating biofilms, termed “pellicles,” which are formed at the air–liquid interface of a static liquid culture [8] (Fig. 1b). Biofilm formation on the surfaces of polystyrene plates was quantified using three different media (LB medium, M9 minimal medium, and KB medium) that are routinely used in general microbiology techniques. According to the manufacturer’s information and the recipe we used for medium preparation, total nitrogen concentration was 1.9, 0.3, and 3.1 g/L in LB medium, M9 minimal medium, and KB medium, respectively. Therefore, in comparison with the nutrient-poor M9 minimal medium, LB and KB media are nutrient-rich media with different types of carbon sources. To monitor the population of planktonic cells that did not participate in biofilm structures, the turbidity at 620 nm (OD620) was measured before quantification of biofilm formation in 96-well plates. Vigorous growth was observed in KB and LB media (ranging from 0.38 to 1.81 of OD620 at 24 h) but not in M9 minimal medium (ranging from 0.04 to 0.28 of OD620 at 24 h) (Fig. 2). Of the 6 strains tested, biofilms formed by P. protegens, P. fluorescens, and P. putida were relatively more abundant than those formed by P. stutzeri, P. mendocina, and P. syringae, although the degree of biofilm formation depended on the medium used (Fig. 2). The degree of biofilm formation by P. protegens gradually increased up to 8 h in LB, M9 minimal, and KB media but began to decrease after 24 h (Fig. 2a). Similar trends in biofilm formation were observed for P. fluorescens, P. putida, and P. mendocina, as the amount of biofilms formed peaked at 4 h in LB and KB media (Fig. 2b, c, e). P. fluorescens and P. putida gradually formed biofilms in M9 minimal medium and continued to increase biofilm production up to 48 h. Finally, the amount of biofilms formed by these strains was greater in M9 minimal medium than in LB and KB media (Fig. 2b, c). On the other hand, P. protegens formed biofilms poorly in M9 minimal medium (Fig. 2a). In contrast to these 4 strains, which were able to form biofilms in all media tested, P. stutzeri only formed biofilms in M9 minimal medium (Fig. 2d), and P. syringae did not form biofilms in LB and M9 minimal media but formed a small number in KB medium (Fig. 2f). Thus, the pseudomonads examined differed in their biofilm-forming behavior. Apart from the intrinsic characteristics of bacterial strains, culturing conditions may also influence biofilm formation.
Two different types of biofilms investigated in this study. a Biofilms formation on the inner surfaces of polystyrene plate wells by P. protegens (left) and P. fluorescens (right) in LB medium after 8 h incubation. Ring-shaped biofilms were stained using crystal violet. b Robust pellicles were formed at the air–liquid interface in the static cultures by P. protegens (left), but not by P. fluorescens at 28 °C for 5 days
Time-course analysis of biofilm formation (left) and growth of planktonic cells (right) by a P. protegens, b P. fluorescens, c P. putida, d P. stutzeri, e P. mendocina, and f P. syringae. Biofilm formation was examined at 28 °C in the static culture with LB medium (closed circle), M9 minimal medium (closed triangle), and King B medium (open circle). In prior to quantification of biofilm formation, unattached planktonic cells were monitored at OD620. Data showed the average of 2 independent experiments ± standard deviation
Bacteria significantly increased their planktonic populations under nutrient-rich conditions, as evidenced by the higher turbidity observed at 620 nm (Fig. 2). However, an increase in the size of planktonic populations did not always stimulate biofilm formation. For example, P. fluorescens, P. putida, and P. stutzeri tended to develop planktonic populations in the nutrient-rich media and biofilm populations in the nutrient-poor medium (Fig. 2b, c). These results indicate that nutrient availability in media influences biofilm formation. It has been reported that, with the exception of Escherichia coli O157:H7, bacteria seem to form biofilms in nutrient-rich environments and to detach from biofilms to search for nutrients in nutrient-poor environments [5, 17]. This appears to be the case of biofilm formation by P. protegens, P. fluorescens, and P. mendocina, as the obvious decreases in the amount of biofilms were observed in rich media after 4 or 8 h of incubation may have been due to nutrient deficiency.
Another possible mechanism is the effect of particular components in media on biofilm formation. For example, the importance of cellular ion homeostasis in biofilm formation is indicated by the fact that inactivation of the functional Na+/H+ transporter (e.g. the Sha transporter) increased biofilm formation [26]. Loss of the function of Na+ excretion may cause Na+ hyperaccumulation that negatively affects cellular biological processes. In the case of E. coli, expression of the pga gene, which is responsible for production of biofilm adhesin, is inducible by NaCl stress [9]. These observations implies that high salinity promotes bacterial biofilm formation. P. protegens and P. mendocina, which form more biofilms under nutrient-rich environments, have higher amount of biofilms in LB (containing 218 mM Na+) rather than in KB (containing 22 mM Na+). Phosphate availability can also modulate signaling pathways of biofilm formation via c-di-GMP production, as P. fluorescens formed more biofilms under higher concentration of phosphate [16]. In agreement, the amount of biofilms formed by P. fluorescens was greater in M9 minimal medium (containing 64 mM phosphate) than in LB medium (4.4 mM) and KB medium (0.9 mM) in our study (Fig. 2b). Because P. putida, P. stutzeri, and P. mendocina also preferred to stay in biofilm forms rather than in planktonic forms in M9 minimal medium (Fig. 2c, d, e), some pseudomonads share the same mechanism of biofilm formation through availability of phosphate. In this study, P. fluorescens, P. putida, and P. stutzeri formed more biofilms in M9 minimal medium, which contains glucose as a carbon source, than in LB and KB media. The relevance of carbon source availability to biofilm formation has been shown in E. coli [5] and P. aeruginosa [23]. In particular, glucose plays a key role as a stimulator of biofilm formation [5] and glucose starvation induces biofilm dispersion [10]. Because glucose is one of the most abundant sugar components in the biofilm matrix [8], glucose availability may directly influence biofilm formation. Notably, biofilm formation seemed to be tightly regulated in P. stutzeri, as this bacterium did not form biofilms in rich media (Fig. 2d). The fact that unattached P. stutzeri cells were more abundant in rich media than in the M9 minimal medium suggests that critical cues (such as the availability of the carbon source or nutrition deficiency) may be required for biofilm formation by P. stutzeri.
We also investigated colony morphology on agar plates, as bacteria displaying rugose colonies form more robust biofilms than those displaying smooth colonies [27]. Under the conditions used, all the strains examined formed smooth colonies (Table 1). Therefore, these pseudomonads do not seem to be robust biofilm formers. In addition, pellicle formation was tested, since the pellicle is recognized as a floating type of biofilm found at liquid–air interfaces [8]. Figure 1b shows the pellicles formed by P. protegens after 5 days of static culture. Pellicle formation was also observed in static cultures of P. putida, P. stutzeri, and P. mendocina but not in those of P. fluorescens and P. syringae. Thus, in addition to possessing the ability to form biofilms on solid surfaces (Fig. 2), P. protegens, P. putida, P. stutzeri, and P. mendocina were able to form cell-to-cell aggregates as floating biofilms.
Efficient Biofilm Formers Have Higher Initial Attachment Ability and Cell Surface Hydrophobicity
In general, biofilm formation is triggered when floating or swimming bacteria encounter surfaces; therefore, initial attachment is an essential step in biofilm formation [17]. To examine this ability, the number of attached cells within 15 to 60 min after inoculation in 96-well plates was determined. Gentle pipetting was used to wash away unattached cells to minimize the disruption of the attached cells on the polystyrene plates, because bacterial cells attached at the early stage of biofilm formation are easily removed by rigorous washing. The strain with the highest ability for initial attachment was P. putida (Fig. 3). Three other strains, P. protegens, P. fluorescens, and P. mendocina, were also able to attach to a polystyrene surface within 15 to 60 min; however, attachment was not significantly detected in dense cultures of P. stutzeri and P. syringae (Fig. 3). Initial bacterial attachment leads to consequent biofilm maturation; therefore, a low ability for initial attachment resulted in poor biofilm formation, as seen in P. stutzeri and P. syringae.
Initial attachment ability of pseudomonads grown in LB medium at 28 °C. Bacterial cells attached to inner surfaces of polystyrene plates were quantified at 15 min (black bar), 30 min (gray bar), and 60 min (white bar) as described in materials and methods. Data showed the average of 2 independent experiments ± standard deviation
Cell surface hydrophobicity contributes to bacterial surface attachment and thus biofilm formation [6]. In this study, we evaluated the surface hydrophobicity of bacterial cells using a hydrocarbon-based method of analysis that is often used in biofilm studies [31]. As shown in Fig. 4, P. putida had the highest cell surface hydrophobicity, and the other strains had relatively hydrophilic cell surfaces. It is likely that possessing cell surface hydrophobicity contributes to the increased ability for initial attachment. Therefore, the biofilm formation observed in P. putida likely occurred through hydrophobic interactions with polystyrene materials.
EPS Production Does Not Always Facilitate Biofilm Formation
When establishing biofilm structures, bacteria produce EPS to adhere persistently to attachment sites. To investigate whether EPS is produced in dynamic culturing environments such as those found in shaking but not in static cultures, the amount of EPS released in the liquid medium was quantified using anthrone-reacting substances. Although P. protegens formed rich biofilms in the static cultures (Fig. 2a), this strain poorly produced EPS in shaking cultures (Fig. 5). This observation indicates that P. protegens may tightly regulate EPS production and only release it in response to environmental cues. Notably, P. syringae produced more EPS than the other pseudomonads. Because P. syringae is a poor biofilm former (Fig. 2f), EPS released from this bacterium may have different role, probably as a kind of pathogenic mechanism rather than as an agent for biofilm maturation [18]. The amount of EPS attached to cell surfaces was also quantified using a red dye (Congo red) that binds to EPS [14, 27]. Only P. mendocina had surface-attached EPS, at a concentration of 0.54 ± 0.06 μg/mL (data not shown). Production of surface-attached EPS has also been observed in hyperbiofilm-forming bacteria; thus, surface-attached EPS could play a role in facilitating cell-to-cell aggregation [14, 27]. Surface-attached EPS appears to participate in promoting biofilm formation in the case of P. mendocina, but this characteristic seemed to be unique among the pseudomonads examined in this study.
Because the bacteria used in this study belong to the same family, Pseudomonadaceae, these bacteria may share large amounts of genomic information [24]. In P. aeruginosa, the model bacterium for biofilm research, the loci related to biofilm formation were identified as the pel and psl loci [8, 11]. These clusters are predicted to encode proteins for polysaccharides synthesis and transport, which are essential for biofilm formation. A search of genomic databases revealed that the pel gene cluster is conserved in P. protegens and P. syringae, whereas the psl gene cluster is conserved in P. protegens. The genomes of P. fluorescens, P. putida, and P. stutzeri do not seem to have complete pel or psl gene clusters. Therefore, these strains seem to differ in regards to their regulatory mechanisms for biofilm formation.
In this study, we characterized the biofilm-forming ability of plant-associated pseudomonads. Investigation of biofilm-related phenotypes such as initial attachment, cell surface hydrophobicity, and EPS production revealed that different bacterial species have different characteristics that facilitate biofilm formation. For example, P. putida possesses cell surface hydrophobicity, which is advantageous for the initial attachment at the start of biofilm formation, whereas P. mendocina produces cell surface-attached EPS, which promotes the formation of cell-to-cell aggregation, and thereby biofilm formation. The pseudomonads examined also had different manners of biofilm formation that could be affected by nutrient availability, suggesting the existence of complicated regulatory mechanisms for biofilm formation. Roles of each components (minerals, nitrogen, carbon, etc.) in media that affect bacterial growth should be also studied to understand mechanisms of biofilm formation. Since biofilm formation causes persistent colonization [22], a better understanding of its mechanisms in plant-associated bacteria will provide useful information about interactions between plants and bacteria.
References
Beauregard PB, Chai Y, Vlamakis H, Losick R, Kolter R (2013) Bacillus subtilis biofilm induction by plant polysaccharides. Proc Natl Acad Sci USA 110(17):E1621–E1630. doi:10.1073/pnas.1218984110
Davies D (2003) Understanding biofilm resistance to antibacterial agents. Nat Rev Drug Discov 2(2):114–122. doi:10.1038/nrd1008
Davies DG, Marques CN (2009) A fatty acid messenger is responsible for inducing dispersion in microbial biofilms. J Bacteriol 191(5):1393–1403. doi:10.1128/JB.01214-08
Davies DG, Parsek MR, Pearson JP, Iglewski BH, Costerton JW, Greenberg EP (1998) The involvement of cell-to-cell signals in the development of a bacterial biofilm. Science 280(5361):295–298
Dewanti R, Wong AC (1995) Influence of culture conditions on biofilm formation by Escherichia coli O157:h7. Int J Food Microbiol 26(2):147–164
Dunne WM Jr (2002) Bacterial adhesion: seen any good biofilms lately? Clin Microbiol Rev 15(2):155–166
Egamberdiyeva D (2005) Characterization of Pseudomonas species isolated from the rhizosphere of plants grown in serozem soil, semi arid region of Uzbekistan. Sci World J 5:501–509. doi:10.1100/tsw.2005.64
Friedman L, Kolter R (2004) Genes involved in matrix formation in Pseudomonas aeruginosa PA14 biofilms. Mol Microbiol 51(3):675–690
Goller C, Wang X, Itoh Y, Romeo T (2006) The cation-responsive protein NhaR of Escherichia coli activates pgaABCD transcription, required for production of the biofilm adhesin poly-beta-1,6-N-acetyl-D-glucosamine. J Bacteriol 188(23):8022–8032. doi:10.1128/JB.01106-06
Huynh TT, McDougald D, Klebensberger J, Al Qarni B, Barraud N, Rice SA, Kjelleberg S, Schleheck D (2012) Glucose starvation-induced dispersal of Pseudomonas aeruginosa biofilms is cAMP and energy dependent. PLoS ONE 7(8):e42874. doi:10.1371/journal.pone.0042874
Jackson KD, Starkey M, Kremer S, Parsek MR, Wozniak DJ (2004) Identification of psl, a locus encoding a potential exopolysaccharide that is essential for Pseudomonas aeruginosa PAO1 biofilm formation. J Bacteriol 186(14):4466–4475. doi:10.1128/JB.186.14.4466-4475.2004
Klausen M, Heydorn A, Ragas P, Lambertsen L, Aaes-Jorgensen A, Molin S, Tolker-Nielsen T (2003) Biofilm formation by Pseudomonas aeruginosa wild type, flagella and type IV pili mutants. Mol Microbiol 48(6):1511–1524
Lakshmanan V, Kitto SL, Caplan JL, Hsueh YH, Kearns DB, Wu YS, Bais HP (2012) Microbe-associated molecular patterns-triggered root responses mediate beneficial rhizobacterial recruitment in Arabidopsis. Plant Physiol 160(3):1642–1661. doi:10.1104/pp.112.200386
Lee VT, Matewish JM, Kessler JL, Hyodo M, Hayakawa Y, Lory S (2007) A cyclic-di-GMP receptor required for bacterial exopolysaccharide production. Mol Microbiol 65(6):1474–1484. doi:10.1111/j.1365-2958.2007.05879.x
Loper JE, Kobayashi DY, Paulsen IT (2007) The genomic sequence of Pseudomonas fluorescens Pf-5: insights into biological control. Phytopathology 97(2):233–238. doi:10.1094/PHYTO-97-2-0233
Monds RD, Newell PD, Gross RH, O’Toole GA (2007) Phosphate-dependent modulation of c-di-GMP levels regulates Pseudomonas fluorescens Pf0-1 biofilm formation by controlling secretion of the adhesin LapA. Mol Microbiol 63(3):656–679. doi:10.1111/j.1365-2958.2006.05539.x
O’Toole G, Kaplan HB, Kolter R (2000) Biofilm formation as microbial development. Annu Rev Microbiol 54:49–79. doi:10.1146/annurev.micro.54.1.49
Osman SF, Fett WF, Fishman ML (1986) Exopolysaccharides of the phytopathogen Pseudomonas syringae pv. glycinea. J Bacteriol 166(1):66–71
Paulsen IT, Press CM, Ravel J, Kobayashi DY, Myers GS, Mavrodi DV, DeBoy RT, Seshadri R, Ren Q, Madupu R, Dodson RJ, Durkin AS, Brinkac LM, Daugherty SC, Sullivan SA, Rosovitz MJ, Gwinn ML, Zhou L, Schneider DJ, Cartinhour SW, Nelson WC, Weidman J, Watkins K, Tran K, Khouri H, Pierson EA, Pierson LS 3rd, Thomashow LS, Loper JE (2005) Complete genome sequence of the plant commensal Pseudomonas fluorescens Pf-5. Nat Biotechnol 23(7):873–878. doi:10.1038/nbt1110
Rich JJ, Hirano SS, Willis DK (1992) Pathovar-specific requirement for the Pseudomonas syringae lemA gene in disease lesion formation. Appl Environ Microbiol 58(5):1440–1446
Ross P, Mayer R, Weinhouse H, Amikam D, Huggirat Y, Benziman M, de Vroom E, Fidder A, de Paus P, Sliedregt LA et al (1990) The cyclic diguanylic acid regulatory system of cellulose synthesis in Acetobacter xylinum. Chemical synthesis and biological activity of cyclic nucleotide dimer, trimer, and phosphothioate derivatives. J Biol Chem 265(31):18933–18943
Ryder C, Byrd M, Wozniak DJ (2007) Role of polysaccharides in Pseudomonas aeruginosa biofilm development. Curr Opin Microbiol 10(6):644–648. doi:10.1016/j.mib.2007.09.010
Sauer K, Cullen MC, Rickard AH, Zeef LA, Davies DG, Gilbert P (2004) Characterization of nutrient-induced dispersion in Pseudomonas aeruginosa PAO1 biofilm. J Bacteriol 186(21):7312–7326. doi:10.1128/JB.186.21.7312-7326.2004
Silby MW, Cerdeno-Tarraga AM, Vernikos GS, Giddens SR, Jackson RW, Preston GM, Zhang XX, Moon CD, Gehrig SM, Godfrey SA, Knight CG, Malone JG, Robinson Z, Spiers AJ, Harris S, Challis GL, Yaxley AM, Harris D, Seeger K, Murphy L, Rutter S, Squares R, Quail MA, Saunders E, Mavromatis K, Brettin TS, Bentley SD, Hothersall J, Stephens E, Thomas CM, Parkhill J, Levy SB, Rainey PB, Thomson NR (2009) Genomic and genetic analyses of diversity and plant interactions of Pseudomonas fluorescens. Genome Biol 10(5):R51. doi:10.1186/gb-2009-10-5-r51
Ueda A, Attila C, Whiteley M, Wood TK (2009) Uracil influences quorum sensing and biofilm formation in Pseudomonas aeruginosa and fluorouracil is an antagonist. Microb Biotechnol 2(1):62–74. doi:10.1111/j.1751-7915.2008.00060.x
Ueda A, Wood TK (2008) Potassium and sodium transporters of Pseudomonas aeruginosa regulate virulence to barley. Appl Microbiol Biotechnol 79(5):843–858. doi:10.1007/s00253-008-1483-5
Ueda A, Wood TK (2009) Connecting quorum sensing, c-di-GMP, pel polysaccharide, and biofilm formation in Pseudomonas aeruginosa through tyrosine phosphatase TpbA (PA3885). PLoS Pathog 5(6):e1000483. doi:10.1371/journal.ppat.1000483
Ueda A, Wood TK (2010) Tyrosine phosphatase TpbA of Pseudomonas aeruginosa controls extracellular DNA via cyclic diguanylic acid concentrations. Environ Microbiol Rep 2(3):449–455. doi:10.1111/j.1758-2229.2010.00171.x
Whitchurch CB, Tolker-Nielsen T, Ragas PC, Mattick JS (2002) Extracellular DNA required for bacterial biofilm formation. Science 295(5559):1487. doi:10.1126/science.295.5559.1487
Yan Y, Yang J, Dou Y, Chen M, Ping S, Peng J, Lu W, Zhang W, Yao Z, Li H, Liu W, He S, Geng L, Zhang X, Yang F, Yu H, Zhan Y, Li D, Lin Z, Wang Y, Elmerich C, Lin M, Jin Q (2008) Nitrogen fixation island and rhizosphere competence traits in the genome of root-associated Pseudomonas stutzeri A1501. Proc Natl Acad Sci USA 105(21):7564–7569. doi:10.1073/pnas.0801093105
Zhang XS, Garcia-Contreras R, Wood TK (2007) YcfR (BhsA) influences Escherichia coli biofilm formation through stress response and surface hydrophobicity. J Bacteriol 189(8):3051–3062. doi:10.1128/JB.01832-06
Acknowledgments
We are grateful to Professors George A. O’Toole (P. protegens Pf-5, P. fluorescens Pf0-1), Juan Ruis Ramos (P. putida KT2440), Steven Lindow (P. syringae B728a) for kindly providing the strains. We are also grateful to NBRC (P. mendocina NBRC 14162) and Pasteur Institute (P. stutzeri A1501) for distributing the strains. This research was supported in part by the grants from Takano Life Science Research Foundation and the Institute for Fermentation, Osaka.
Author information
Authors and Affiliations
Corresponding author
Rights and permissions
About this article
Cite this article
Ueda, A., Saneoka, H. Characterization of the Ability to Form Biofilms by Plant-Associated Pseudomonas Species. Curr Microbiol 70, 506–513 (2015). https://doi.org/10.1007/s00284-014-0749-7
Received:
Accepted:
Published:
Issue Date:
DOI: https://doi.org/10.1007/s00284-014-0749-7